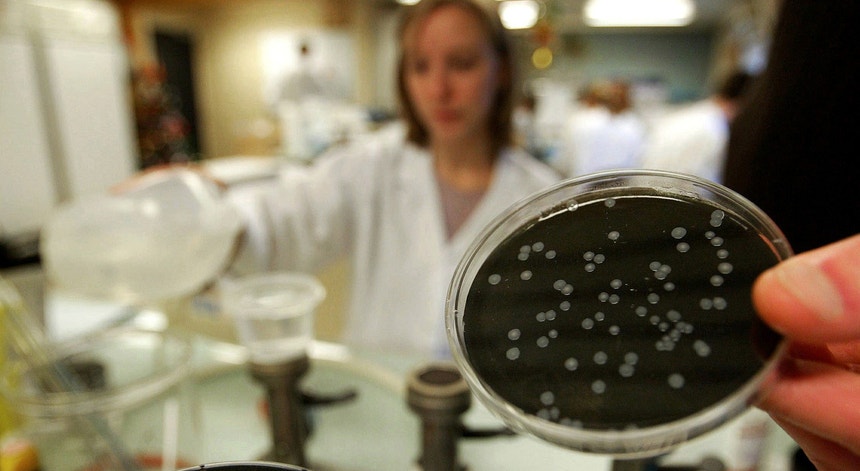

País
Número de casos de legionella sobe para 38
A Direção-geral de Saúde divulgou o balanço atualizado sobre o surto de legionella no São Francisco Xavier. Revela que há três novos casos de infeção com a doença dos legionários. Permanecem cinco pessoas internadas nos cuidados intensivos.
As primeiras vítimas do surto foram registadas a 31 de outubro, de acordo com o boletim.
Dados da DGS indicam que a maioria (63 por cento) são mulheres e os doentes infetados têm a maior parte (68 por cento) idades iguais ou superiores a 70 anos.
Foram ainda registados dois óbitos, um homem e uma mulher, ocorridos a 6 de novembro.
Os corpos foram entregues terça-feira às famílias, obrigando a PSP a recolhê-los durante os respetivos velórios, a mando do Ministério Público, que alegou precisar de fazer as autópsias para seguir com a investigação.
Segundo o Ministério Público, os óbitos não tinham sido comunicado à justiça. O Ministério Público foi então informado que “os corpos já haviam sido entregues às famílias” e decidiu “ordenar o encaminhamento dos corpos para o Instituto de Medicina Legal com vista à realização dos exames referidos”.
A recolha dos corpos foi efetuada na última noite, quando já decorriam os velórios. As famílias não escondem a indignação.
Já o ministro da Saúde lamenta toda a situação.
Autoridades confiantes no controlo do surto
Terça-feira, a diretora-geral da Saúde, Graça Freitas, afirmou em conferência de imprensa, confiar que o surto de 'legionella' no Hospital São Francisco Xavier estivesse a estabilizar e a entrar numa fase com menos casos.
"O número de casos novos está perfeitamente estabilizado. Tudo indica que o surto vai entrar numa fase com menos casos por dia até que se extinguirá. Esperam-se para os próximos dias relativamente poucos casos", indicou na altura Graças Freitas.
Ontem as autoridades de saúde destacaram ainda indícios de que as medidas corretivas já estavam a surtir efeito.
O ministro da Saúde já admitiu que houve "falhas" na prevenção do surto assinalado no Hospital São Francisco Xavier. Mas Adalberto Campos Fernandes considerou que os portugueses "têm condições para confiar no Serviço Nacional de Saúde, que respondeu com grande firmeza e competência".
Pelo contrário, o líder parlamentar do PSD, Hugo Soares, acusou o Estado de "falhar onde não pode falhar", no Serviço Nacional de Saúde, referindo-se ao surto de 'legionella' no Hospital de São Francisco Xavier, em Lisboa.
Terça-feira, no final de uma reunião com a administração do hospital, Hugo Soares afirmou que o partido irá aguardar pelas análises que estão a ser feitas sobre as causas do surto, mas manifestou já uma certeza.
"O Estado falhou, falhou onde não pode falhar, dentro do Serviço Nacional de Saúde (SNS). As pessoas vêm cá para se curar e, ao contrário, neste caso vieram cá para adoecer".
"Efeito positivo" das medidas
O surto de legionella surgiu dias antes da greve dos Médicos mas não chegou para a impedir, como explicou Mário Jorge neves, da Federação Nacional dos Médicos à Antena 1.
Dos cinco doentes ainda internados em unidades de cuidados intensivos e que inspiram mais cuidados têm apresentado uma situação estável. Quatro deles estão em unidades públicas de saúde e um outro num hospital privado, por opção própria, revelou terça-feira a diretora-geral de Saúde.
Graça Freitas lembrou que os doentes infetados com legionella são geralmente pessoas mais idosas e com várias doenças associadas.
A diretora-geral da Saúde recordou que na sexta-feira o hospital de São Francisco Xavier notificou a DGS sobre o diagnóstico de doença dos legionários, provocada pela legionella, em três doentes. Nesse mesmo dia foi feita análises aos circuitos de águas dos hospitais.
No dia seguinte, sábado, foram aplicadas medidas corretivas, como choque térmico e químico, bem como o encerramento das torres de refrigeração.
No dia seguinte foram colhidas novas amostras de água cujos resultados ainda preliminares apontam para um "efeito positivo das medidas que foram tomadas".
C/Lusa
Dados da DGS indicam que a maioria (63 por cento) são mulheres e os doentes infetados têm a maior parte (68 por cento) idades iguais ou superiores a 70 anos.
Foram ainda registados dois óbitos, um homem e uma mulher, ocorridos a 6 de novembro.
Os corpos foram entregues terça-feira às famílias, obrigando a PSP a recolhê-los durante os respetivos velórios, a mando do Ministério Público, que alegou precisar de fazer as autópsias para seguir com a investigação.
Segundo o Ministério Público, os óbitos não tinham sido comunicado à justiça. O Ministério Público foi então informado que “os corpos já haviam sido entregues às famílias” e decidiu “ordenar o encaminhamento dos corpos para o Instituto de Medicina Legal com vista à realização dos exames referidos”.
A recolha dos corpos foi efetuada na última noite, quando já decorriam os velórios. As famílias não escondem a indignação.
Já o ministro da Saúde lamenta toda a situação.
Autoridades confiantes no controlo do surto
Terça-feira, a diretora-geral da Saúde, Graça Freitas, afirmou em conferência de imprensa, confiar que o surto de 'legionella' no Hospital São Francisco Xavier estivesse a estabilizar e a entrar numa fase com menos casos.
"O número de casos novos está perfeitamente estabilizado. Tudo indica que o surto vai entrar numa fase com menos casos por dia até que se extinguirá. Esperam-se para os próximos dias relativamente poucos casos", indicou na altura Graças Freitas.
Ontem as autoridades de saúde destacaram ainda indícios de que as medidas corretivas já estavam a surtir efeito.
O ministro da Saúde já admitiu que houve "falhas" na prevenção do surto assinalado no Hospital São Francisco Xavier. Mas Adalberto Campos Fernandes considerou que os portugueses "têm condições para confiar no Serviço Nacional de Saúde, que respondeu com grande firmeza e competência".
Pelo contrário, o líder parlamentar do PSD, Hugo Soares, acusou o Estado de "falhar onde não pode falhar", no Serviço Nacional de Saúde, referindo-se ao surto de 'legionella' no Hospital de São Francisco Xavier, em Lisboa.
Terça-feira, no final de uma reunião com a administração do hospital, Hugo Soares afirmou que o partido irá aguardar pelas análises que estão a ser feitas sobre as causas do surto, mas manifestou já uma certeza.
"O Estado falhou, falhou onde não pode falhar, dentro do Serviço Nacional de Saúde (SNS). As pessoas vêm cá para se curar e, ao contrário, neste caso vieram cá para adoecer".
"Efeito positivo" das medidas
O surto de legionella surgiu dias antes da greve dos Médicos mas não chegou para a impedir, como explicou Mário Jorge neves, da Federação Nacional dos Médicos à Antena 1.
Dos cinco doentes ainda internados em unidades de cuidados intensivos e que inspiram mais cuidados têm apresentado uma situação estável. Quatro deles estão em unidades públicas de saúde e um outro num hospital privado, por opção própria, revelou terça-feira a diretora-geral de Saúde.
Graça Freitas lembrou que os doentes infetados com legionella são geralmente pessoas mais idosas e com várias doenças associadas.
A diretora-geral da Saúde recordou que na sexta-feira o hospital de São Francisco Xavier notificou a DGS sobre o diagnóstico de doença dos legionários, provocada pela legionella, em três doentes. Nesse mesmo dia foi feita análises aos circuitos de águas dos hospitais.
No dia seguinte, sábado, foram aplicadas medidas corretivas, como choque térmico e químico, bem como o encerramento das torres de refrigeração.
No dia seguinte foram colhidas novas amostras de água cujos resultados ainda preliminares apontam para um "efeito positivo das medidas que foram tomadas".
C/Lusa


